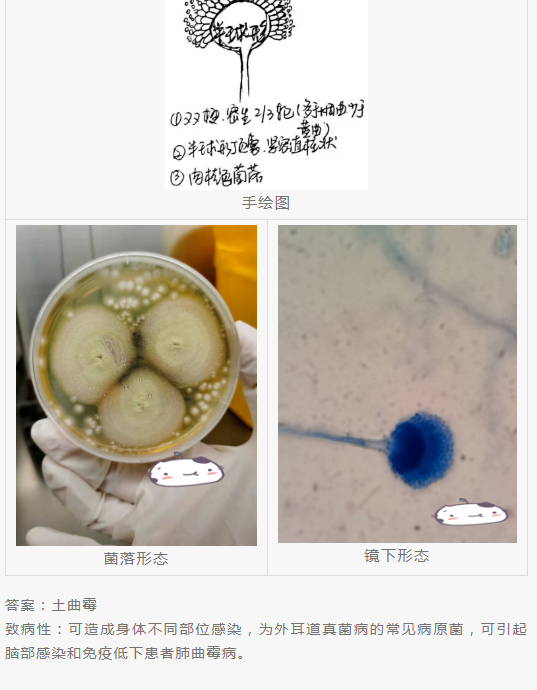

传播文明,引领风尚,关注随州文明建设
您需要 登录 才可以下载或查看,没有账号?立即注册
x
您觉得检验报告单中真菌、霉菌、酵母菌、念珠菌等项目是一种菌吗?当这些不同的名称现身于大便常规、白带常规、各种细菌或真菌培养的报告中,您是否会为之迷惑?
近日,随州市中心医院 医学检验科的小姐姐 为了让大家更好的了解“真菌”的故事亲手绘制了一组“真菌”美图▼ 曾几何时,我们习惯性的旧称呼已悄然转型,如霉菌性阴道炎,已改为阴道念珠菌病,白色念珠菌应该叫白念珠菌。也许曾经以为带毛的霉菌就是毛霉,后来了解毛霉只是众多带毛的霉菌中的一个小小的种,它上面还有毛霉属,根霉属,根毛霉属,横梗霉属,小克银汉霉属等,而他们都属于毛霉目。带毛的霉菌其实叫丝状真菌,它的家族很庞大,毛霉目真菌也只是其中一大类,还有曲霉属、青霉属、镰刀菌属、赛多孢菌属、暗色真菌等其他丝状真菌。
为什么真菌的概念会感觉傻傻分不清楚,今天,通过这些猜菌小游戏为大家分享关于真菌的手绘美图与镜下形态。

猜菌小游戏结束后大家是不是对“菌”有了更深的认识我们平时肉眼看不见的真菌不少是致病菌种因此,真菌科普一定要了解
1、真菌培养需要多少天?常见真菌菌落成熟所需时间:真菌比细菌长得慢,一般培养时间为4周,念珠菌属、曲霉属、毛霉目生长较快,一周之内可生长,皮肤癣菌生长较慢,需要1-2周,还有更慢的真菌,如组织胞浆菌需要6-8周等。也就是说我们日常三天出报告的真菌培养,只能报告念珠菌属、曲霉属、毛霉目和生长快速的真菌,像隐球菌、皮肤癣菌或更多的丝状真菌就有可能会漏检,特殊需求的真菌培养需要延长培养时间。
是不是报了真菌就要抗真菌治疗呢?真菌培养和细菌培养一样,我们无法通过一份不会说话的标本来判断是定植、感染还是污染,而真菌被污染的可能性更高,需结合临床综合考虑。特别是尿液和痰液中培养出的念珠菌意义有限,定植或污染的可能大,需多次复查或者寻找更多的真菌感染证据才可靠。我们报的真菌或细菌,仅对此次检测负责,它来自标本,并不能判断病人情况和采样方法及来源,检出菌不一定是致病菌,所以药敏结果或天然耐药的备注也仅供参考,需结合临床综合判断。

注:此表引自卢洪洲、钱雪琴、徐和平老师主编的《医学真菌检验与图解》,-表示无活性;±表示可能有活性;+表示有活性,三线治疗药物(临床上活性最低);++表示有活性,二线治疗药物(临床上活性不够高);+++表示有活性,一线治疗药物(临床上活性较高)
霉菌(丝状真菌)到底有哪些呢?要弄清楚霉菌,就必须从真菌分类说起。
(一)真菌分类真菌分为7个门、10个亚门、35个纲、12个亚纲和129个目,包括担子菌门,子囊菌门,壶菌门,微孢子菌门,芽枝霉门,球囊菌门和新丽鞭毛菌门。这个分类概念我认为太专业,且真菌命名及分类改变较多,要记住着实不易,那就按菌落形态大概了解下常见菌属吧!
真菌按菌落形态分:酵母型菌(隐球菌属)、类酵母型菌(念珠菌属、马拉色菌属)、丝状菌(曲霉属、毛霉目等)、双相真菌(马尔尼菲篮状菌、粗球孢子菌、副球孢子菌、组织胞浆菌、申克孢子丝菌)。
(二)丝状真菌的形态学鉴定丝状真菌的形态学鉴定以菌落形态和镜检特征为主要依据,还有血清学、质谱、核酸、测序等分子生物学检测手段。有的丝状真菌有典型结构:如曲霉属有分生孢子头,毛霉目有孢子囊,青霉属有帚状枝等,日常工作中如果有真菌图谱在实践中比对学习更能积累经验。
| 
